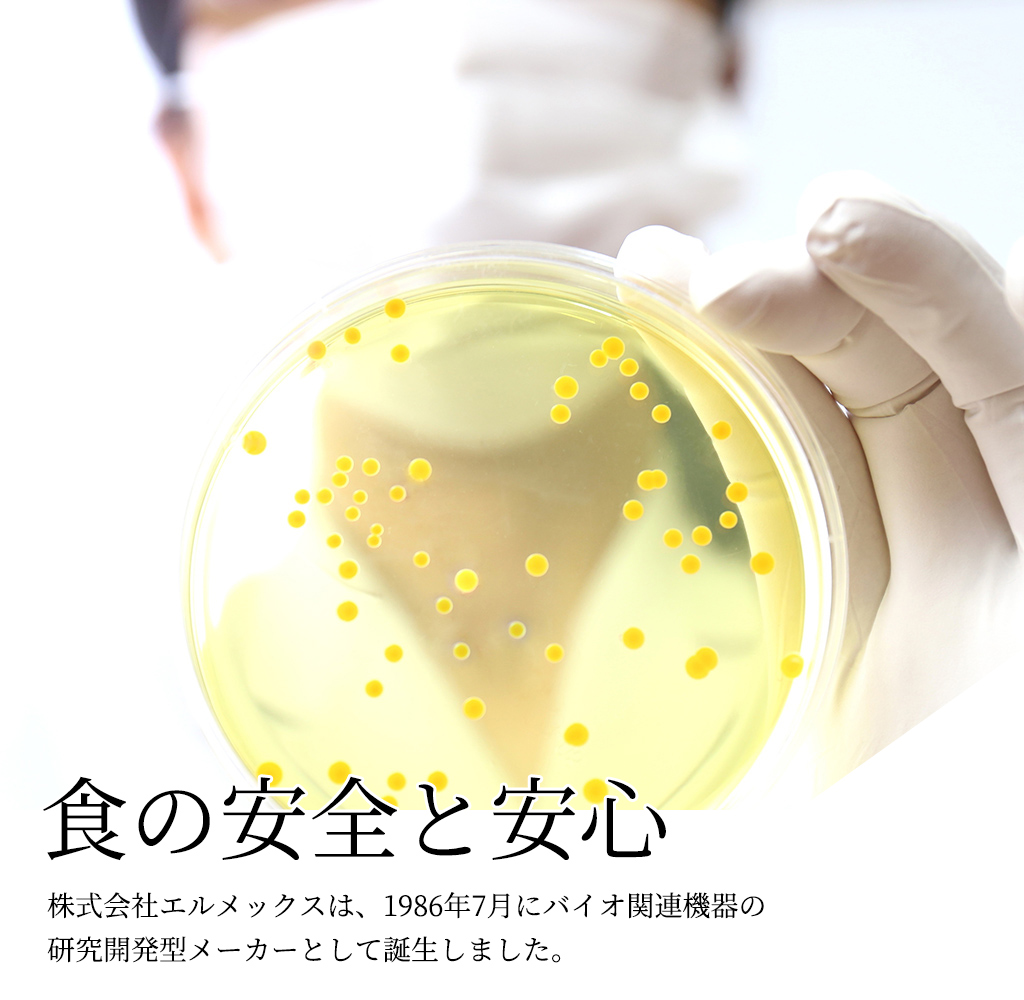

新入荷
再入荷
AE-228 ブロック用接着剤 ピタブロック 1本(1kg) セメダイン
 タイムセール
タイムセール
終了まで
00
00
00
999円以上お買上げで送料無料(※)
999円以上お買上げで代引き手数料無料
999円以上お買上げで代引き手数料無料
通販と店舗では販売価格や税表示が異なる場合がございます。また店頭ではすでに品切れの場合もございます。予めご了承ください。
商品詳細情報
| 管理番号 |
新品 :32068228847
中古 :32068228847-1 |
メーカー | ee656bbceb2 | 発売日 | 2025-05-22 07:41 | 定価 | 15950円 | ||
|---|---|---|---|---|---|---|---|---|---|
| カテゴリ | |||||||||

![■AS フローメータ RK1710-1〔品番:2799701〕【8668071:0】[送料別途見積り][掲外取寄][店頭受取不可]](https://tshop.r10s.jp/hcvalor-eshop/cabinet/trusco/8668/trusco-8668071.jpg)
![■AS フローメータ RK1710-5〔品番:2799702〕【8668072:0】[送料別途見積り][掲外取寄][店頭受取不可]](https://tshop.r10s.jp/hcvalor-eshop/cabinet/trusco/8668/trusco-8668072.jpg)
![■長野 普通形圧力計(D枠/埋込形) 75Φ 形番:AC15 35MPa(検査成績書付)〔品番:AC1513135MPAIR〕【6170239:0】[送料別途見積り][法人・事業所限定][外直送][店頭受取不可]](https://tshop.r10s.jp/hcvalor-eshop/cabinet/trusco/6170/trusco-6170239.jpg)
![■長野 普通形圧力計(D枠/埋込形) 100Φ 形番:AE15 25MPa(検査成績書付)〔品番:AE1514125MPAIR〕【6179642:0】[送料別途見積り][法人・事業所限定][外直送][店頭受取不可]](https://tshop.r10s.jp/hcvalor-eshop/cabinet/trusco/6179/trusco-6179642.jpg)

![■長野 普通形圧力計(D枠/埋込形) 75Φ 形番:AC15 35MPa(検査成績書付)〔品番:AC1523135MPAIR〕【6178066:0】[送料別途見積り][法人・事業所限定][外直送][店頭受取不可]](https://tshop.r10s.jp/hcvalor-eshop/cabinet/trusco/6178/trusco-6178066.jpg)


![エスコ [軸用スナップリング]メンテナンスキット EA949R-3](https://tshop.r10s.jp/tuzukiya/cabinet/0/0/9308/e22-75309.jpg)











